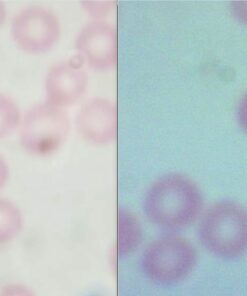
AmScope B120C-E1 40X-2500X LED Biological Binocular Compound Microscope with 3D Double Layer Mechanical Stage + 1.0 MP USB Digital Camera Imager 1.0 MP Camera 30 61nRP hF6zL
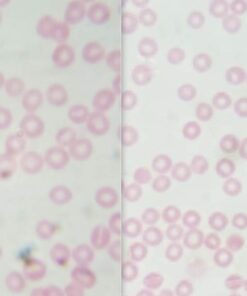
AmScope B120C-E1 40X-2500X LED Biological Binocular Compound Microscope with 3D Double Layer Mechanical Stage + 1.0 MP USB Digital Camera Imager 1.0 MP Camera 31 61udzmwwxxL

AmScope B120C-E1 40X-2500X LED Biological Binocular Compound Microscope with 3D Double Layer Mechanical Stage + 1.0 MP USB Digital Camera Imager
Description
A professional biological microscope for education, clinics and vets, and
entry-level research. 6 wide-field magnifications levels from 40X to 2500X for
viewing a large range of specimens including fixed and live cells, bacteria,
and more. Binocular head provides flexibility and comfort with advanced
adjustment features. Bright, daylight-balanced LED illumination uses our
specialized fly-eye lens for improved uniformity and contrast.
Features:
- 40X to 2500X expanded magnification range using high-quality, color-coded objective lenses, and 10X and 25X eyepieces for six unique settings ideal for viewing.
- Forward-facing nosepiece with 4x, 10x, 40xS (spring), and 100xS (spring, oil) DIN achromatic objectives that provide color correction of magnified images at five magnifications
- Siedentopf binocular head fixed 30-degree vertical inclination to reduce eye and neck strain, and 360-degree rotation capability to provide a more comprehensive view and enable sharing
- The Binocular head with pairs of 10x widefield and 25x widefield eyepieces with 53 to 77mm inter-pupillary adjustment, allows you to achieve six widefield magnification settings: 40X Magnification, 100X Magnification, 250X Magnification, 400X Magnification, 1000X Magnification & 2500X Magnification
- Brightfield, LED illumination, and 1.25 NA Abbe condenser with iris diaphragm and light control, along with a large 3D double layer mechanical Stage with coaxial coarse and fine focus knobs gives a clear examining field of view
- Double-layer mechanical stage, with 1.0mm stage divisions, locks slide into place and provides precise slide manipulation along the X- and Y-axis to allow coordinates to be recorded, enabling the viewer to return to a specific locations on the slide
- Includes a 1MP, USB 2.0, digital eyepiece camera utilizing professional microscopy software for capturing photos and videos on your PC or Mac
Product Details:
- Light Source Type: LED
- Material: Plastic, Metal
- Color: White, Black
- Product Dimensions: 11.81"L x 9.06"W x 16.54"H
- Real Angle of View: 30 Degrees
- Magnification Maximum: 2500 x
- Item Weight: 0.01 Ounces
- Voltage: 110 Volts (AC)
- Brand: AmScope
- Compatible Devices: Personal Computer
- Product Dimensions: 16.54 x 11.81 x 9.06 inches
- Item Weight: 0.01 ounces
- Item model number: B120C-E1
- Is Discontinued By Manufacturer: No
- Date First Available: October 24, 2012
- Manufacturer: United Scope LLC.
- Country of Origin: China

JUST MY SIZE Women's Plus Size Pintuck Top 20 Plum Port
Medieval Warrior 8th Century Viking Sword Full Tang Tempered Battle Ready Handmade Sword Sharp
Old-fashioned Malted Milk Powder by Hoosier Hill Farm, 1.5 lbs.
HE 27" Gold Ninja Sword Stainless Steel with Sheath
3M AquaPure AP431 Scale Inhibition Replacement Cartridge, Easy Change High Capacity Water Filter for AP430SS Replacement Water Filter
Ashley Recliner Cable and Handle Replacement Overall Length 39.5" Exposed Cable 4.75"
B15 Complete Extra Strength, Pangamic Acid, 500mg 90 Capsules
Three Rooker Art Ties Mens Van Gogh Irises Painting Necktie
Honda 72560-VH8-642AH Semi-Matic Trimmer Head
Adams Job Work Order Book, 5.56 x 8.44 Inch, 3-Part, Carbonless, 33 Sets, White and Canary (T5868)
Original Sears Craftsman Husqvarna Part # 194231X427 WHEEL & TIRE ASSY. FRONT DRIV 1
Chicken Feeder-Holds 20 Pounds-Pellets-Crumbles-Grain in Bucket - for 21st Century Chicken Owners - Inside or Outside of Coop - Use with Nipple Waterer 2 Feed Ports - Corner (4-6 Hens)
Nertpow Winter Daily Beanie Hat for Men Women, Warm Fleece Lined Thermal Trendy Thick Knit Skull Cable Cuff Cap
PS3 Ear Force PX21 Gaming Headset
11" Stainless Steel Wolverine Fantasy Claw Set of 2
Ace Martial Arts Supply Japanese Samurai Katana Sword Maintenance Cleaning Kit
Tram 1607-HC 46-Inch VHF Marine Antenna One Size
Authentic Battle Ready Viking Long sword
Dell AC511 USB Wired SoundBar
iPearl mCover Hard Shell Case for 10.1-inch ASUS Chromebook Flip C100PA Series Laptop (Purple) Purple
Smead Pressboard Classification File Folder with SafeSHIELD Fasteners, 2 Dividers, 2" Expansion, Letter Size, Gray/Green, 10 per Box (14076)
Attmu 50 PCS Reusable Fastening Cable Ties, Microfiber Cloth 6-Inch Hook and Loop Cord Ties, Black A-50 Black
Creative Teaching Press Stripes and Stitches Border (1040)
35 Oz Bella Sun Luci Sun Dried Tomatoes Julienne Cut In Olive Oil
97371(4-Pack) Porcelain Steel Heat Plate Replacement For Select Grill Master ..